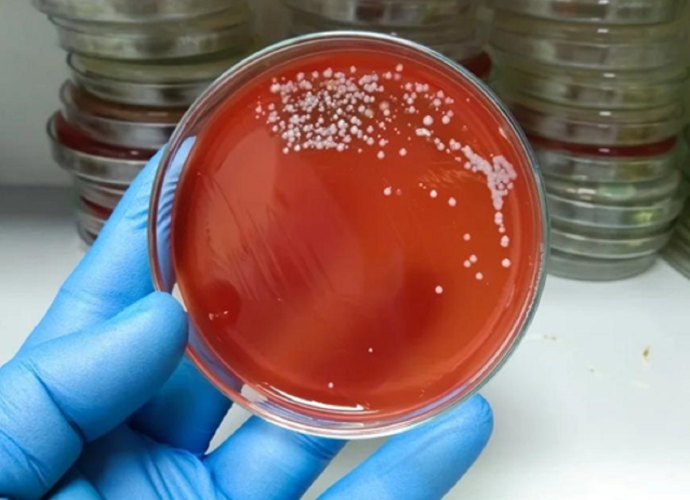

14°C
ЗСУ виводять сили з кількох позицій на Донеччині
18.03.2025 11:43

ЗСУ прийняли рішення вивести сили з кількох невигідних позицій на Донеччині.
"На одній із ділянок фронту ухвалено рішення щодо відведення сил та засобів з невигідних позицій. Це дало можливість не лише зберегти бійців, а й покращити нашу оборону. Ворог несе втрати, і ми маємо змогу діяти ефективніше", – повідомив командир тактичної групи "Велика Новосілка" Сергій Наєв.
Він на цій посаді перебуває уже 2 другий місяць.
Наєв прозвітував, що за останній місяць, завдяки спільній роботі розвідників, операторів дронів, артилеристів, мінометників, танкістів та піхоти, вдалося знищити понад 30 одиниць ворожої бронетехніки й більше 2000 окупантів.
"Це відчутно зменшило кількість ворожих атак на нашому напрямку", – додав він.
Останні новини
Читайте також